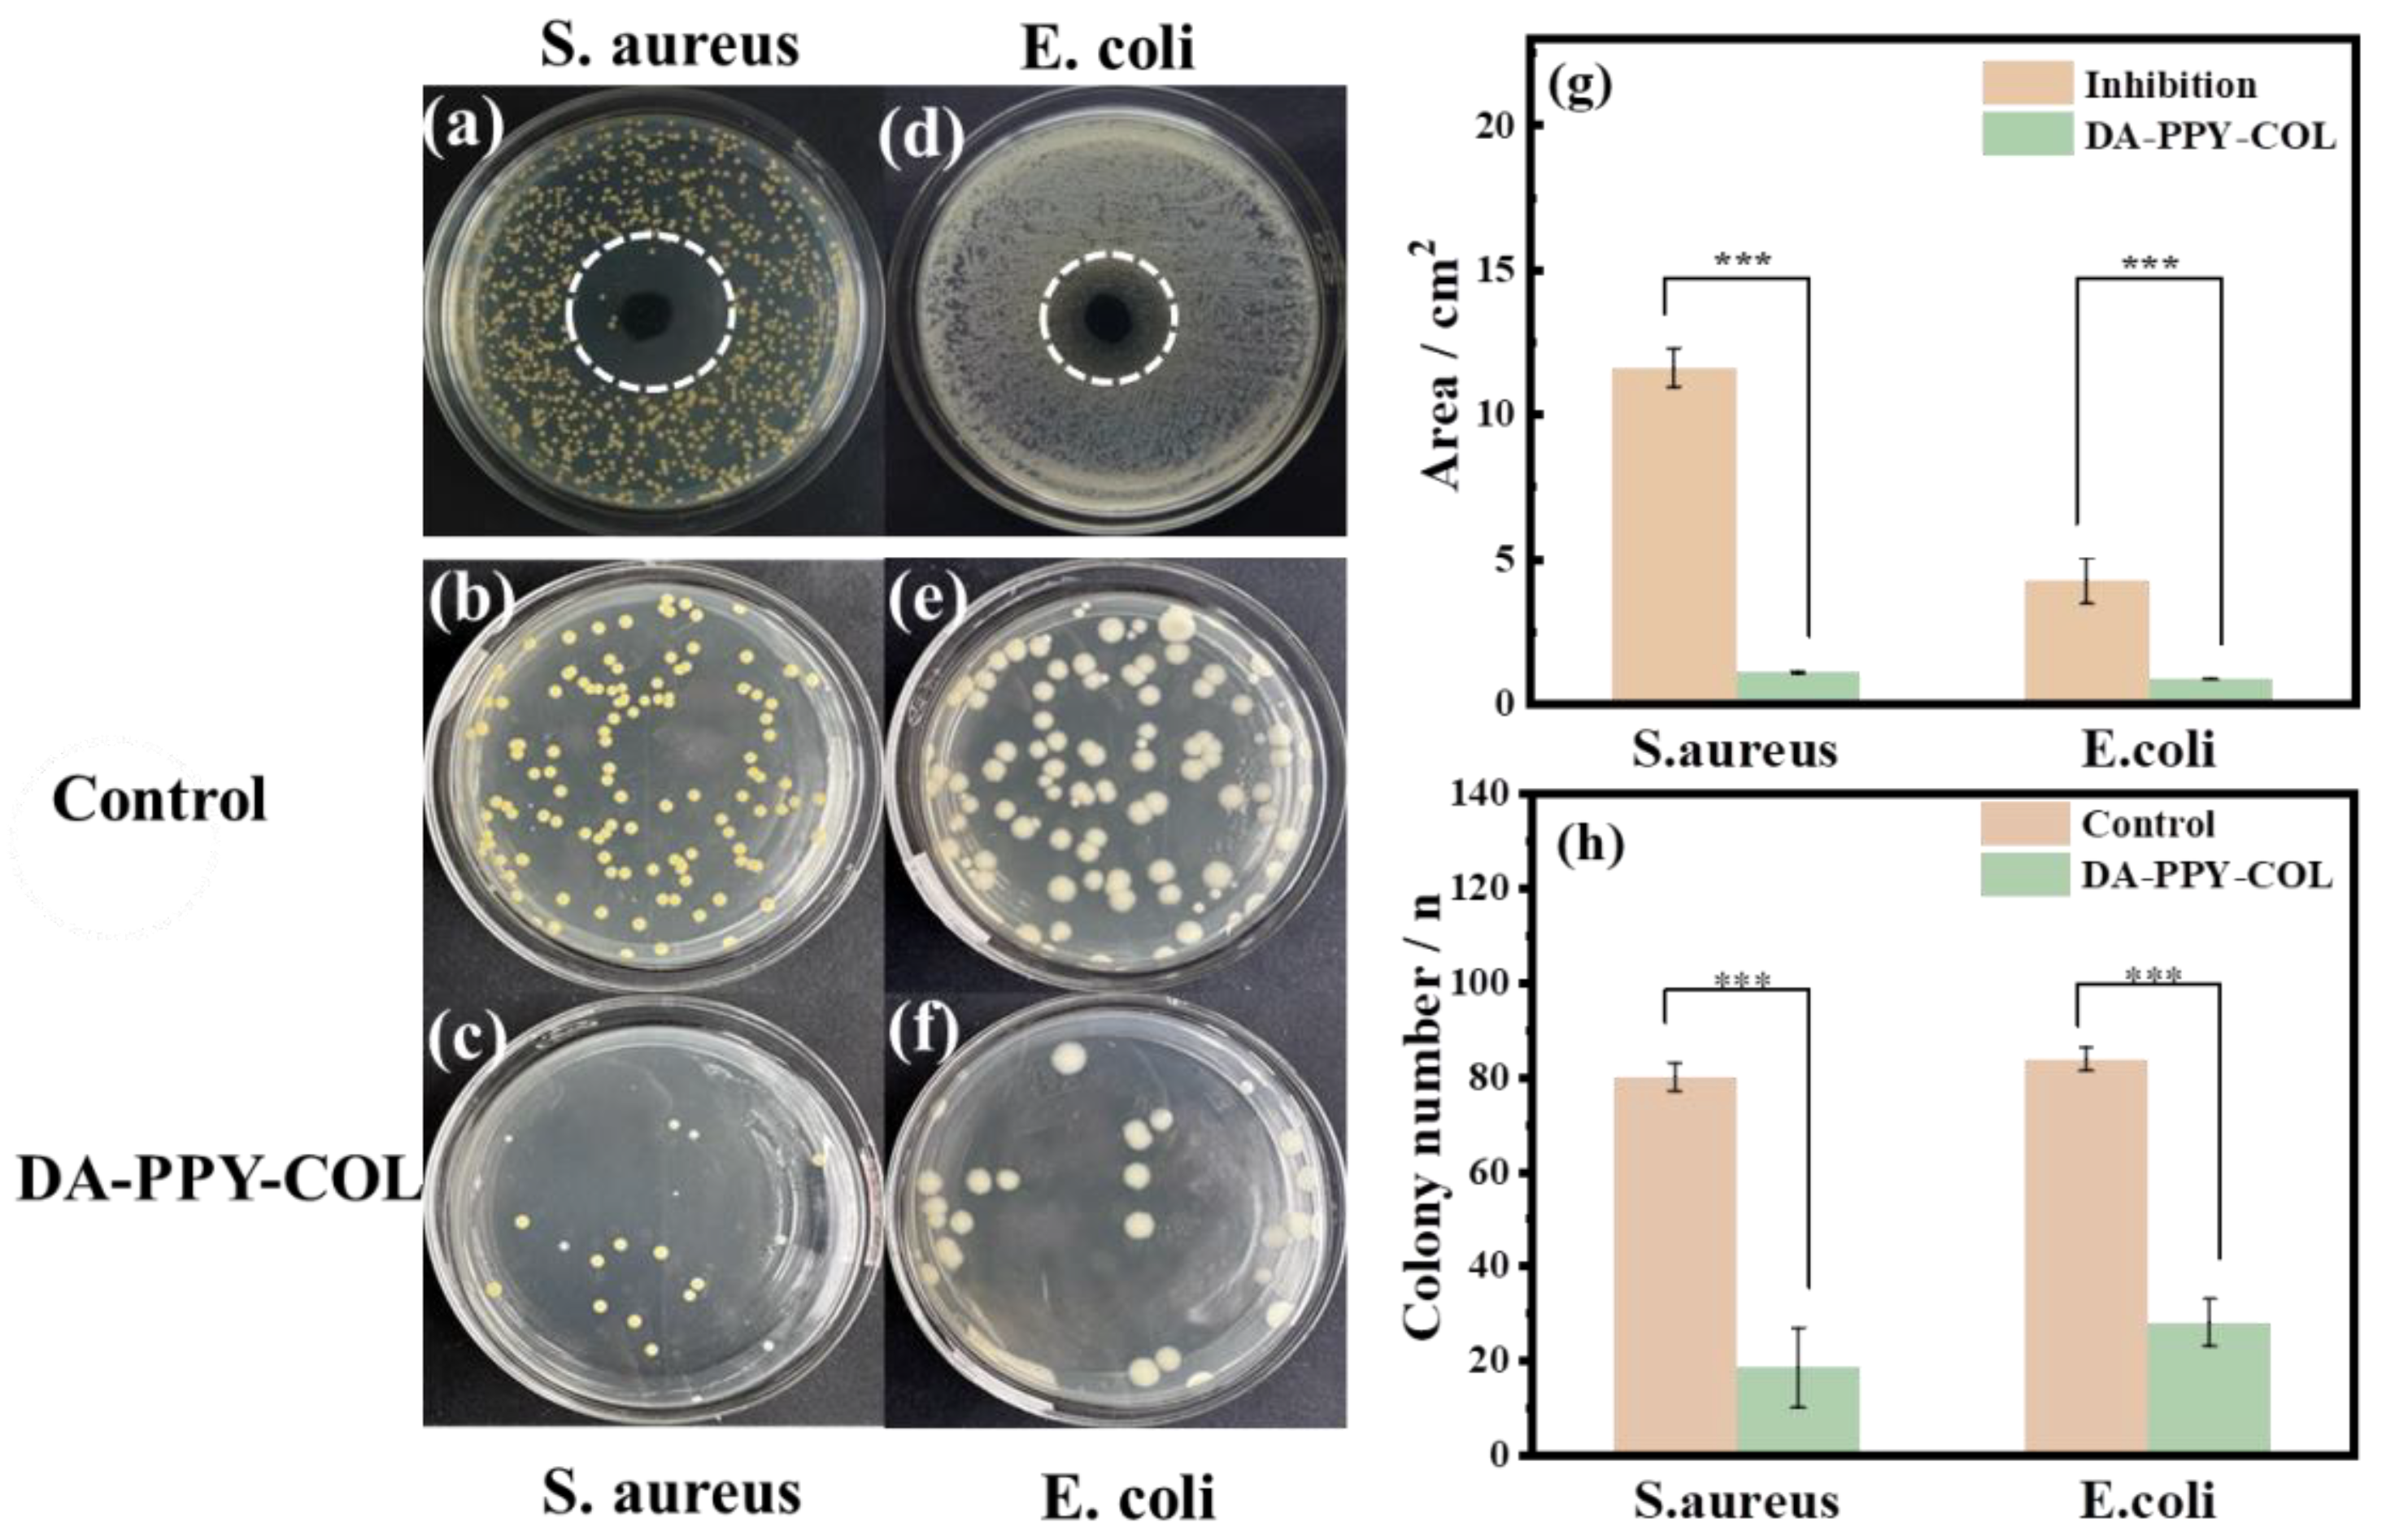
Molecules 29 05728 g004

Adhesive, Biocompatible, Antibacterial, and Degradable Collagen-Based Conductive Hydrogel as Strain Sensor for Human Motion Monitoring
Abstract
1. Introduction
2. Results and Discussion
2.1. Structural Characterization of Hydrogels
2.2. Adhesion Property of the DA-PPY-COL Hydrogel
2.3. Biocompatibility of DA-PPY-COL Hydrogel
2.4. Antibacterial Properties of Collagen-Based Hydrogels
2.5. Biodegradable Properties
2.6. Electroactivity Measurement
2.7. Real-Time Motion Detection Using the DA-PPY-COL Hydrogel Strain Sensor
3. Materials and Methods
3.1. Raw Materials
3.2. Preparation of DA-PPY-COL Hydrogels
3.3. Materials Characterization
3.4. Antibacterial Activity Evaluation
3.5. Cytotoxicity Evaluation
3.5.1. Cell Dead-Viable Staining
3.5.2. CCK-8 Cell Proliferation Experiment
3.6. Degradability Test
3.7. Electroactivity Measurement
3.8. Sensing Capability of the Hydrogels
3.9. Statistical Analysis
4. Conclusions
Supplementary Materials
Author Contributions
Funding
Institutional Review Board Statement
Informed Consent Statement
Data Availability Statement
Conflicts of Interest
References
- Duan, Z.; Jiang, Y.; Huang, Q.; Yuan, Z.; Zhao, Q.; Wang, S.; Zhang, Y.; Tai, H. A do-it-yourself approach to achieving a flexible pressure sensor using daily use materials. J. Mater. Chem. C 2021, 9, 13659–13667. [Google Scholar] [CrossRef]
- Zhang, Z.; Li, Q.; Xu, L.; Tian, W.; Li, Z. High-performance flexible temperature sensors based on laser-irradiated Ag-MWCNTs/PEDOT: PSS. ACS Appl. Mater. Interfaces 2024, 16, 6078–6087. [Google Scholar] [CrossRef]
- Han, Y.; Wei, H.; Du, Y.; Li, Z.; Feng, S.; Huang, B.; Xu, D. Ultrasensitive flexible thermal sensor arrays based on high-thermopower ionic thermoelectric hydrogel. Adv. Sci. 2023, 10, 2302685. [Google Scholar] [CrossRef] [PubMed]
- Yang, J.; Gao, M.; Wang, K.; Yu, H.; Lv, R.; Fu, M. Robust double-network polyvinyl alcohol-polypyrrole hydrogels as high-performance electrodes for flexible supercapacitors. J. Colloid Interface Sci. 2023, 652, 540–548. [Google Scholar]
- Tao, X.; Ye, S.; Zhu, K.; Dou, L.; Cui, P.; Ma, J.; Zhao, C.; Wei, X.; Guo, L.; Hojjati-Najafabadi, A.; et al. ATMP doped conductive PANI/CNTs composite hydrogel electrodes toward high energy density flexible supercapacitors. ACS Appl. Energy Mater. 2023, 6, 8177–8188. [Google Scholar] [CrossRef]
- Ling, Q.; Fan, X.; Ling, M.; Liu, J.; Zhao, L.; Gu, H. Collagen-based organohydrogel strain sensor with self-healing and adhesive properties for detecting human motion. ACS Appl. Mater. Interfaces 2023, 15, 12350–12362. [Google Scholar] [CrossRef]
- Wang, T.; Yi, W.; Zhang, Y.; Wu, H.; Fan, H.; Zhao, J.; Wang, S. Sodium alginate hydrogel containing platelet-rich plasma for wound healing. Colloid Surf. B 2023, 222, 113096. [Google Scholar] [CrossRef]
- Liu, F.; Wang, L.; Zhai, X.; Ji, S.; Ye, J.; Zhu, Z.; Teng, C.; Dong, W.; Wei, W. A multi-functional double cross-linked chitosan hydrogel with tunable mechanical and antibacterial properties for skin wound dressing. Carbohyd. Polym. 2023, 322, 121344. [Google Scholar] [CrossRef] [PubMed]
- Aycan, D.; Karaca, F.; Alemdar, N. Development of hyaluronic acid-based electroconductive hydrogel as a sensitive non-enzymatic glucose sensor. Mater. Today Commun. 2023, 35, 105745. [Google Scholar] [CrossRef]
- Chen, M.; Wan, H.; Hu, Y.; Zhao, F.; An, X.; Lu, A. Rationally designed cellulose hydrogel for an ultrasensitive pressure sensor. Mater. Horiz. 2023, 10, 4510–4520. [Google Scholar] [CrossRef]
- Li, X.; Zhang, S.; Li, X.; Lu, L.; Cui, B.; Yuan, C.; Guo, L.; Yu, B.; Chai, Q. Starch/polyvinyl alcohol with ionic liquid/graphene oxide enabled highly tough, conductive and freezing-resistance hydrogels for multimodal wearable sensors. Carbohyd. Polym. 2023, 320, 121262. [Google Scholar] [CrossRef] [PubMed]
- Roshanbinfar, K.; Kolesnik-Gray, M.; Angeloni, M.; Schruefer, S.; Fiedler, M.; Schubert, D.; Ferrazzi, F.; Krstic, V.; Engel, F. Collagen hydrogel containing polyethylenimine-gold nanoparticles for drug release and enhanced beating properties of engineered cardiac tissues. Adv. Healthc. Mater. 2023, 12, 2202408. [Google Scholar] [CrossRef] [PubMed]
- He, Z.; Shen, J.; Lan, M.; Gu, H. Collagen fiber-reinforced, tough and adaptive conductive organohydrogel e-skin for multimodal sensing applications. J. Mater. Chem. B 2024, 12, 6940–6958. [Google Scholar] [CrossRef] [PubMed]
- Zhao, R.; Luo, J.; Ke, T.; Zhang, J.; Astruc, D.; Zhou, J.; Gu, H. Ultra-Tough, highly stable and Self-Adhesive Goatskin-Based intelligent Multi-Functional organogel e-skin as Temperature, Humidity, Strain, and bioelectric four-mode sensors for health monitoring. Chem. Eng. J. 2024, 485, 149816. [Google Scholar] [CrossRef]
- Liu, X.; Cui, B.; Wang, X.; Zheng, M.; Bai, Z.; Yue, O.; Fei, Y.; Jiang, H. Nature-skin-derived e-skin as versatile “wound therapy-health monitoring” bioelectronic skin-scaffolds: Skin to bio-e-skin. Adv. Healthc. Mater. 2023, 12, 2202971. [Google Scholar] [CrossRef]
- Zhu, L.; Yu, Z.; Li, S.; Xu, C.; Hou, Y.; Liao, L.; Xu, Y.; Zhang, J.; Wei, B.; Wen, W.; et al. Recent advances on collagen biomaterial: From extraction, cross-linking to tissue regeneration. Polym. Rev. 2024, 64, 1031–1059. [Google Scholar] [CrossRef]
- Han, Q.; Koyama, T.; Watabe, S.; Nagashima, Y.; Ishizaki, S. Isolation and characterization of collagen and collagen peptides with hyaluronidase inhibition activity derived from the skin of marlin (Istiophoridae). Molecules 2023, 28, 889. [Google Scholar] [CrossRef]
- Wei, B.; Huang, S.; Li, K.; Wu, H.; Liu, Y.; Zhang, J.; Hou, Y.; Zhu, L.; Xu, C.; Wang, L.; et al. Recognition of MCF-7 breast cancer cells using native collagen probes: Collagen source effect. Int. J. Biol. Macromol. 2024, 282, 136661. [Google Scholar] [CrossRef]
- Cai, P.; Zheng, B.; Xu, Y.; Li, B.; Liu, Z.; Huang, Y.; Ye, J.; Xiao, M. Multifunctional fish-skin collagen-based hydrogel sealant with dual-dynamic-bond cross-linked for rapid hemostasis and accelerated wound healing. Int. J. Biol. Macromol. 2024, 266, 131179. [Google Scholar] [CrossRef]
- Song, B.; Fan, X.; Shen, J.; Gu, H. Ultra-stable and self-healing coordinated collagen-based multifunctional double-network organohydrogel e-skin for multimodal sensing monitoring of strain-resistance, bioelectrode, and self-powered triboelectric nanogenerator. Chem. Eng. J. 2023, 474, 145780. [Google Scholar] [CrossRef]
- Gao, C.; Zheng, D.; Long, B.; Chen, Z.; Zhu, J.; Gao, Q. Anti-swelling and adhesive γ-PGA/PVA/PEDOT: PSS/TA composite conductive hydrogels for underwater wearable sensors. Eur. Polym. J. 2023, 201, 112590. [Google Scholar] [CrossRef]
- Paradee, N.; Thanokiang, J.; Sirivat, A. Conductive poly (2-ethylaniline) dextran-based hydrogels for electrically controlled diclofenac release. Mat. Sci. Eng. C-Mater. 2021, 118, 111346. [Google Scholar] [CrossRef] [PubMed]
- Taha, G.M.; Baseer, R.A.; Kassem, A.F.; Khalil, R. Designing of semiconductive cotton fabrics based on poly (propynyl benzo thiazolone) with UV protection and antibacterial properties. Mat. Sci. Eng. B-Adv. 2022, 283, 115857. [Google Scholar] [CrossRef]
- Nada, A.; Eckstein Andicsová, A.; Mosnáček, J. Irreversible and self-healing electrically conductive hydrogels made of bio-based polymers. Int. J. Mol. Sci. 2022, 23, 842. [Google Scholar] [CrossRef] [PubMed]
- Rahmani, P.; Shojaei, A.; Dickey, M. A highly conductive and ultra-stretchable polyaniline/cellulose nanocrystal/polyacrylamide hydrogel with hydrophobic associations for wearable strain sensors. J. Mater. Chem. A 2024, 12, 9552–9562. [Google Scholar] [CrossRef]
- Hu, S.; Zhou, L.; Tu, L.; Dai, C.; Fan, L.; Zhang, K.; Yao, T.; Chen, J.Q.; Wang, Z.; Xing, J.; et al. Elastomeric conductive hybrid hydrogels with continuous conductive networks. J. Mater. Chem. B 2019, 7, 2389–2397. [Google Scholar] [CrossRef]
- Liu, X.; Shi, H.; Song, F.; Yang, W.; Yang, B.; Ding, D.; Liu, Z.; Hui, L.; Zhang, F. A highly sensitive and anti-freezing conductive strain sensor based on polypyrrole/cellulose nanofiber crosslinked polyvinyl alcohol hydrogel for human motion detection. Int. J. Biol. Macromol. 2024, 257, 128800. [Google Scholar] [CrossRef]
- Zhang, L.; Wu, Y.; Xia, Y.; Jin, L. High capacitance of polypyrrole hydrogel electrode synthesized by polymerization of conjugated pyrrole salt. Electrochim. Acta 2022, 412, 140108. [Google Scholar] [CrossRef]
- He, Y.; Li, Z.; Su, H.; Sun, Y.; Shi, W.; Yi, Y.; Ge, D.; Fan, Z. Pyrrole-doped polydopamine-pyrrole (pda-npy) nanoparticles with tunable size and improved nir absorption for photothermal therapy. Pharmaceuticals 2023, 16, 1642. [Google Scholar] [CrossRef]
- Lei, H.; Zhao, J.; Ma, X.; Li, H.; Fan, D. Antibacterial dual network hydrogels for sensing and human health monitoring. Adv. Healthc. Mater. 2021, 10, 2101089. [Google Scholar] [CrossRef]
- Lv, Y.; Chen, C.; Jin, L.; Zheng, Y.; Wu, S.; Zhang, Y.; Li, Z.; Zhu, S.; Jiang, H.; Cui, Z.; et al. Microwave-excited, antibacterial core-shell BaSO4/BaTi5O11@PPy heterostructures for rapid treatment of S. aureus-infected osteomyelitis. Acta Biomater. 2023, 167, 506–518. [Google Scholar] [CrossRef] [PubMed]
- Maruthapandi, M.; Saravanan, A.; Gupta, A.; Luong, J.; Gedanken, A. Antimicrobial activities of conducting polymers and their composites. Macromol 2022, 2, 78–99. [Google Scholar] [CrossRef]
- Borges, M.; Nagay, B.; Costa, R.; Souza, J.; Mathew, M.; Barão, V. Recent advances of polypyrrole conducting polymer film for biomedical application: Toward a viable platform for cell-microbial interactions. Adv. Colloid Interface Sci. 2023, 314, 102860. [Google Scholar] [CrossRef] [PubMed]
- Ding, X.; Duan, S.; Ding, X.; Liu, R.; Xu, F. Versatile antibacterial materials: An emerging arsenal for combatting bacterial pathogens. Adv. Funct. Mater. 2018, 28, 1802140. [Google Scholar] [CrossRef]
- Zhang, W.; Pan, Z.; Ma, J.; Wei, L.; Chen, Z.; Wang, J. Degradable cross-linked collagen fiber/MXene composite aerogels as a high-performing sensitive pressure sensor. ACS Sustain. Chem. Eng. 2022, 10, 1408–1418. [Google Scholar] [CrossRef]
- Guo, B.; Zhong, Y.; Chen, X.; Yu, S.; Bai, J. 3D printing of electrically conductive and degradable hydrogel for epidermal strain sensor. Compos. Commun. 2023, 37, 101454. [Google Scholar] [CrossRef]
- Li, W.; Yang, Y.; Zhang, X.; Liu, Y.; Luan, J. Fabrication and assembly of supercapacitors based on Ni-based MOFs and their derivative materials for enhancing their electrochemical performances. Nanoscale 2024, 16, 16556–16570. [Google Scholar] [CrossRef]
- Li, L.; Ai, Z.; Wu, J.; Liu, Z.; Huang, M.; GAO, Y.; Bai, H. A robust polyaniline hydrogel electrode enables superior rate capability at ultrahigh mass loadings. Nat. Commun. 2024, 15, 6591. [Google Scholar] [CrossRef]
- Ge, J.; Zhu, M.; Eisner, E.; Yin, Y.; Dong, H.; Karnaushenko, D.; Karnaushenko, D.D.; Zhu, F.; Ma, L.; Schmidt, O. Imperceptible supercapacitors with high area-specific capacitance. Small 2021, 17, 2101704. [Google Scholar] [CrossRef]

Disclaimer/Publisher’s Note: The statements, opinions and data contained in all publications are solely those of the individual author(s) and contributor(s) and not of MDPI and/or the editor(s). MDPI and/or the editor(s) disclaim responsibility for any injury to people or property resulting from any ideas, methods, instructions or products referred to in the content. |
© 2024 by the authors. Licensee MDPI, Basel, Switzerland. This article is an open access article distributed under the terms and conditions of the Creative Commons Attribution (CC BY) license (https://creativecommons.org/licenses/by/4.0/).
Share and Cite
Liao, L.; Zhang, J.; Ding, J.; Xu, C.; Zhu, L.; Hou, Y.; Li, S.; Zhang, J.; Wei, B.; Wang, H. Adhesive, Biocompatible, Antibacterial, and Degradable Collagen-Based Conductive Hydrogel as Strain Sensor for Human Motion Monitoring. Molecules 2024, 29, 5728. https://doi.org/10.3390/molecules29235728
Liao L, Zhang J, Ding J, Xu C, Zhu L, Hou Y, Li S, Zhang J, Wei B, Wang H. Adhesive, Biocompatible, Antibacterial, and Degradable Collagen-Based Conductive Hydrogel as Strain Sensor for Human Motion Monitoring. Molecules. 2024; 29(23):5728. https://doi.org/10.3390/molecules29235728
Chicago/Turabian StyleLiao, Lixia, Jiyuan Zhang, Jiaqi Ding, Chengzhi Xu, Lian Zhu, Yuanjing Hou, Sheng Li, Juntao Zhang, Benmei Wei, and Haibo Wang. 2024. "Adhesive, Biocompatible, Antibacterial, and Degradable Collagen-Based Conductive Hydrogel as Strain Sensor for Human Motion Monitoring" Molecules 29, no. 23: 5728. https://doi.org/10.3390/molecules29235728
APA StyleLiao, L., Zhang, J., Ding, J., Xu, C., Zhu, L., Hou, Y., Li, S., Zhang, J., Wei, B., & Wang, H. (2024). Adhesive, Biocompatible, Antibacterial, and Degradable Collagen-Based Conductive Hydrogel as Strain Sensor for Human Motion Monitoring. Molecules, 29(23), 5728. https://doi.org/10.3390/molecules29235728

